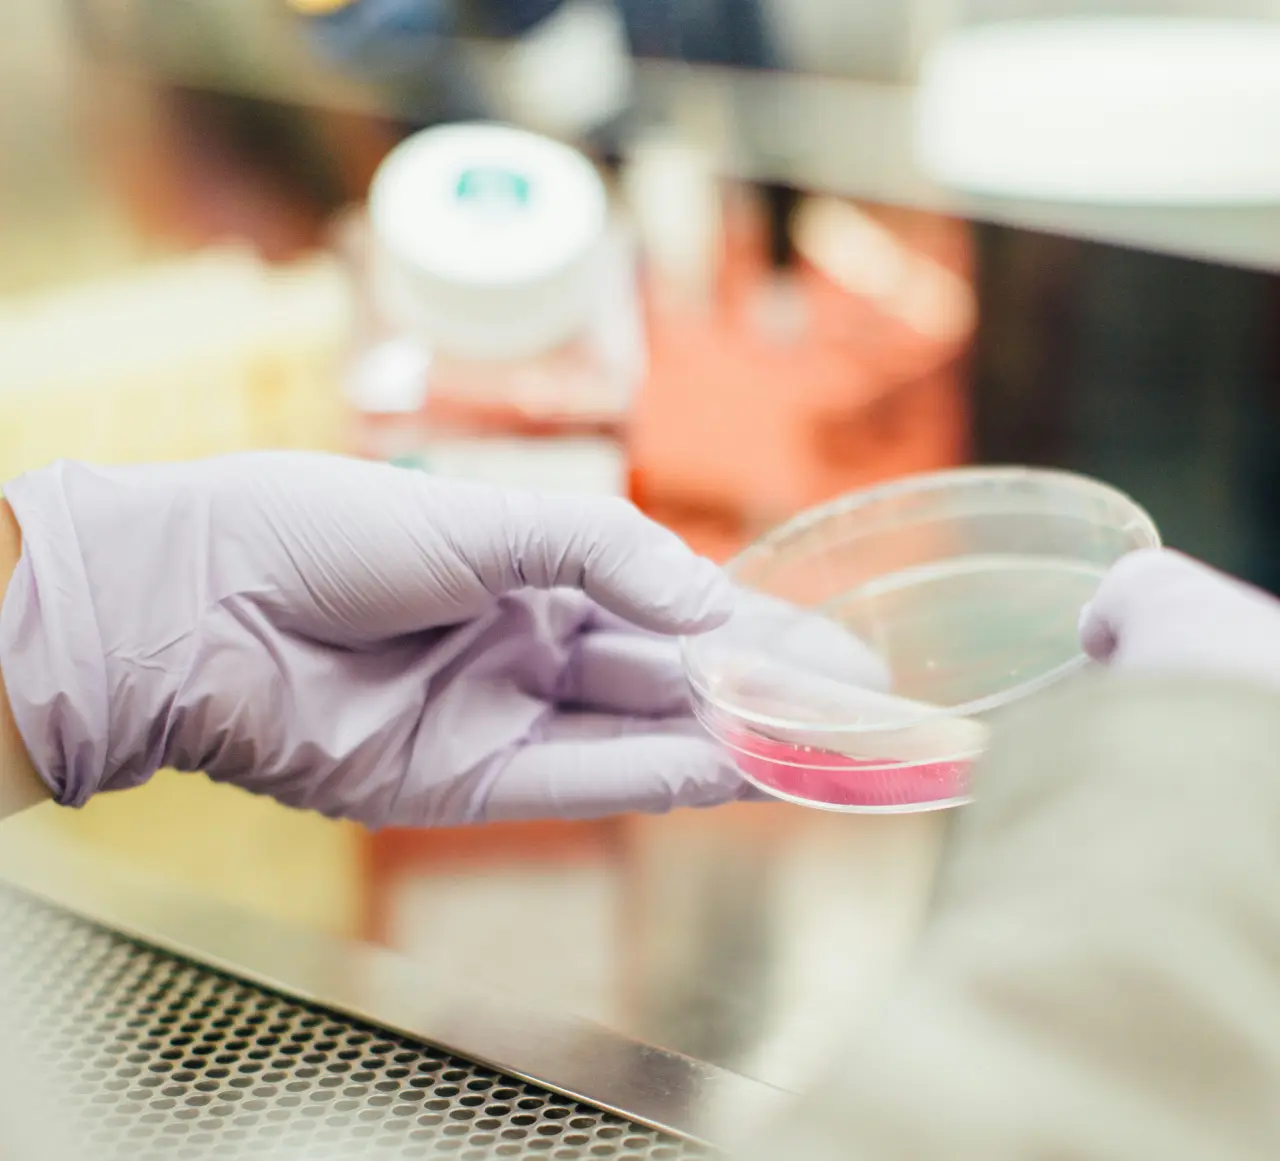
Clinical Researcher working

Epicore Biosystems
Cambridge, Massachusetts, United States
Epicore Biosystems
!
Our biowearables help people work better.
About Epicore Biosystems
Founded by scientists, built for the world.
Epicore Biosystems is a digital health company creating metabolic health solutions and making them accessible to all. Whether you’re a frontline worker, an elite athlete, or a mindful consumer, our innovative biowearables decode the complex health signals in your body and transform them into actionable insights.
What’s in Sweat?
Every drop contains a rich blend of biomarkers, including electrolytes, metabolites, nutrients, proteins, toxins, and so much more.
Our biowearable solutions measure hydration, nutrition, stress, and health-related biomarkers by analyzing sweat in combination with other physiological data.
Description of Services
Our Solutions

Industrial Safety
Ensure a safer workplace through real-time hydration interventions enabled by continuous monitoring of sweat and electrolyte losses, skin temperature, and motion data.

Sports & Fitness
Get hydration and performance feedback with real-time insights on sweat and electrolyte losses to tailor your personalized action plan across workouts.
Clinical Research
Unlock laboratory-based data analyzing a multitude of biomarkers in sweat with an FDA-registered, non-invasive collection and extraction system.

